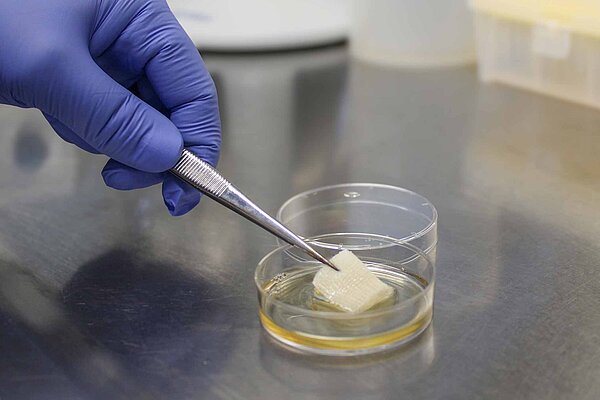

- Industries
-
Materials
 Materials
MaterialsAs a neutral and independent testing service provider, we offer analyses of the highest quality for a wide range of products.
-
Test procedures
 Test procedures
Test proceduresAs a neutral and independent testing service provider, we offer analyses of the highest quality for a wide range of products.
- Accreditation
- Company
- Contact
OMPG - Ostthüringische Materialprüfgesellschaft für Textil und Kunststoffe mbH
Breitscheidstraße 97
07407 Rudolstadt
| Phone | + 49 3672 379 - 0 |
| info@ompg.de |



![[Translate to English:] [Translate to English:]](/fileadmin/_processed_/b/b/csm_brandpruefungen-und-elektroanwendungen_7036bf8d6b.jpg)

![[Translate to English:] [Translate to English:]](/fileadmin/_processed_/8/a/csm_biologische-pruefungen_b330c70d45.jpg)